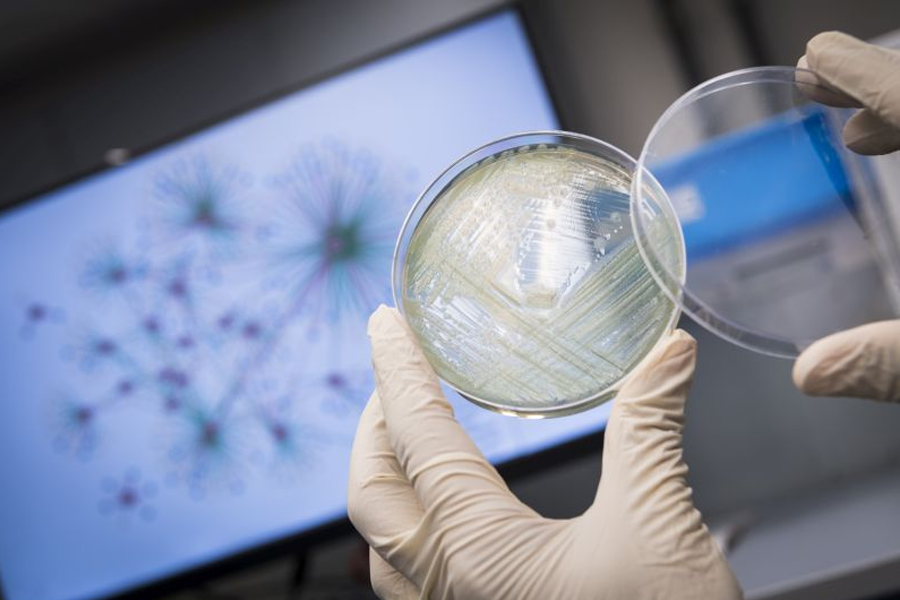

News
We are pleased to announce that Dr. Terrence Lau, Associate Professor and formerly the Associate Head, has been appointed as Acting Head of the Department of Biomedical Sciences from 1 September 2019 until further notice.
We would like to welcome Professor Sheng Chen, who has just joined the Department of Infectious Diseases and Public Health as Professor of Veterinary Bacteriologya
“We are committed to promoting innovation and contributing to the well-being of society, and CityU is pleased to share its education and technology achievements with all sectors,” said Professor Way Kuo, President of CityU.
Professor Dirk Pfeiffer (Chair Professor of One Health) attended the Inception Workshop for the Regional Technical Cooperation Programme on African Swine Fever Emergency Preparedness and Response in East and Southeast Asia. The meeting was held by the Food and Agriculture Organization of the United Nations (FAO) Regional Office for Asia and Pacific (FAORAP) in August in Bangkok, Thailand.
A new Department of Neuroscience has been established on 1 July 2019 under the Jockey Club College of Veterinary Medicine and Life Sciences.
A delegation from the Faculty of Veterinary Medicine at Okayama University of Science in Japan recently visited the Jockey Club College of Veterinary Medicine and Life Sciences to share their experiences of setting up and running a veterinary degree programme in Asia.
As antibiotic resistance is growing and posing a threat on public health, developing new antibiotics has become more urgent than ever. Researchers at City University of Hong Kong (CityU) have recently revealed the virulence regulatory mechanism in Pseudomonas aeruginosa, a superbug which is common in patients with a weak immune system and is resistant to many antibiotics. The findings pave ways for identifying good antibiotic targets for new drug development.
On 26–28 June 2019, BMS held its fourth departmental Research Gala cum Guangdong-Hong Kong-Macau Greater Bay Area Biomedical Forum at Zhongshan, China. The Zhongshan Municipal Government provided much kind support of the event, including the conference venue at the Jinhuayue International Hotel at Zhongshan.